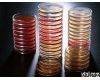
<em>P0060</em> <em>鱼粉</em><em>蛋白胨</em>

CAS:P0060 鱼蛋白胨/鱼粉蛋白胨/F403蛋白胨/蛋白胨F403
- 型号:CAS:P0060
- 产地:上海
- 供应商:上海一基实业有限公司
- 供应商报价:面议
- 标签:鱼蛋白胨/鱼粉蛋白胨/F403蛋白胨/蛋白胨F403,-1,上海一基实业有限公司
| P0060 | 鱼蛋白胨/鱼粉蛋白胨/F403蛋白胨/蛋白胨F403/蛋白胨(鱼粉)/Peptone(Fish) | BR | 250克 | HDL |
| 500克 | OxiodL-85原装 | |||
| P0061 | 大豆蛋白胨/大豆胨/植物蛋白胨/豆胨/Peptone From Soybean | BR | 250克 | HDL |
| P0062 | 聚蛋白胨/多聚蛋白胨/多价蛋白胨/Polypeptone | BR | 250克 | HDL |
| 500克 | 日本制药株式会社原装 | |||
| 10公斤 | 日本制药株式会社原装 | |||
| P0063 | 酪蛋白胨/酪胨/胰酪胨/胰酪蛋白胨/Casitone | BR | 250克 | HDL |
| P0064 | 肉蛋白胨/精致蛋白胨/猪肉蛋白胨/Peptone(From porcine meat) | BR | 500克 | HDL |
| P0065 | 牛肉蛋白胨/肉蛋白胨/Beef Peptone | BR | 250克 | HDL |
| P0066 | 细菌蛋白胨/Bacto Peptone | BR | 250克 | HDL |
| P0067 | 蚕蛹蛋白胨 | BR | 250克 | HDL |
| P0068 | 血粉蛋白胨 | BR | 250克 | HDL |
| P0069 | 全胃蛋白胨 | BR | 250克 | HDL |
| P0071 | Lambda Broth | BR | 100克 | HDL |
| P0070 | 明胶蛋白胨/蛋白胨E/Gelatin Peptone | BR | 250克 | HDL |
| P0072 | 特殊蛋白胨/Peptone Special | BR | 250克 | HDL |
| P0073 | 胃蛋白胨 | BR | 250克 | HDL |